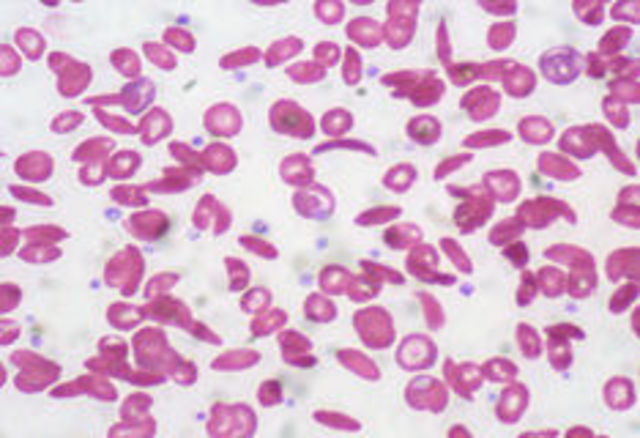
Sickle Cell Disease named

-
Dr. James Herrick first discovered it in one of his dental students after showing pulmonary symptoms, when a blood sample was taken from the student, Herrick saw the deformed red blood cells in a sickle shape, and then later published an article describing the shape of the red blood cell.
-
When Dr. Mason connected all the different cases together, of Sickle Cell, and saw a pattern in all the cases in that the red blood cells were sickle shaped, so he named the disease Sickle Cell. Dr. mason also saw that most of the people with this disease came from African decent, which made people think that Sickle Cell Disease came from people of African decent.
-
The cause of sickle cell disease was unknown until Hahn and Gillespie discovered that the abnormal shape of the red blood cells was due to low oxygen and acidic conditions in the cells.
-
Dr. Janet Watson discovered that the reason why Sickle Cell Disease wasn't found in newborns, that actually had it, is because of the fetal hemoglobin that newborns had which made them have no symptoms of the disease.The higher levels of Fetal hemoglobin present in the newborns blood stream the less likely it was for a physician to spot the disease.
-
A paper was published by a physical chemist named Linus Pauling and in this paper he discussed how the hemoglobin of sickle cell differed from hemoglobin of a regular red blood cell. This was the first time that someone figured out that the reason why people had sickle cell disease was due to the change of a protein structure in the hemoglobin.
-
During this time Vernon Ingram and J.A. Hunt sequenced hemoglobin and showed that the Beta chain in the HbS was different because of one of the amino acids, in normal hemoglobin you would have 2 alpha chains and 2 beta chains without the change in amino acids But in the HbS the beta chain had a mutation which changed the 6th amino acid in the beta chain, thus the cause of sickle cell disease.
-
Once finding out where the production of blood cells took place, which was mostly in the bone marrow, they tried a bone marrow transplant as a cure for people that had really bad anemia and the success rate was high at 90%. The first operation was preformed on an 8 year old girl who had acute leukemia as well as sickle cell disease, and by getting her brothers bone marrow she recovered.
-
Want to make a timeline like this?
Use Timetoast to turn dates, events, milestones, and phases into a clear visual timeline you can build and share. Timetoast is a timeline maker for work, school, research, and stories.